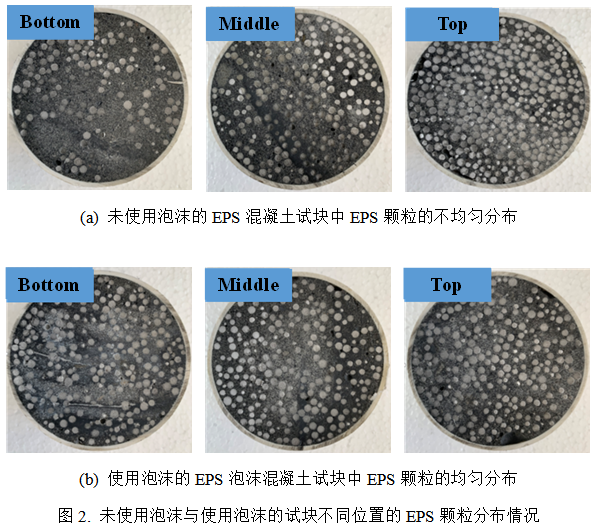

近期,公司张文华教授团队在工程技术领域国际著名期刊《Archives of Civil and Mechanical Engineering》(影响因子4.042)发表了题为 “Dynamic impact compressive performance of expanded polystyrene (EPS)-foamed concrete”的研究论文。(论文链接:https://doi.org/10.1007/s43452-022-00486-6)。
Expanded Polystyrene (EPS)是生产与生活中使用量较大的一种轻质材料,目前对废弃EPS的处理主要分为回收,填埋以及焚烧等方式,然而这些处理方式无法对大量废弃的EPS形成有限的利用,还会严重污染环境。由于EPS材料具有密度低、变形能力优异的特点,因此,将EPS引入到混凝土制作出新型EPS混凝土,可有效提高混凝土的抗动态冲击能力与吸能能力,为EPS材料的有效回收利用提供了新的思路。但是,由于EPS的密度远低于混凝土浆体,将EPS与混凝土浆体搅拌后,极易造成大量EPS颗粒的上浮,由此而产生了各组分材料分布不均匀,各部分之间力学性能差异较大等问题。针对以上问题,论文以发泡剂CAB-35,丙烯酸聚合物成膜稳定剂MP-50H以及亲水性纳米二氧化硅为原材料,通过比例设计,制造出一种能够使EPS颗粒在混凝土浆体中均匀分布的泡沫,进而设计出EPS泡沫混凝土。再使用分离式霍普金森压杆(SHPB)进行抗动态冲击试验,得到不同EPS含量的EPS泡沫混凝土的抗动态冲击与吸能能力。
该研究体现了变废为新的废弃物处理理念,利用泡沫处理后的EPS颗粒在混凝土浆体中均匀分布的特性,有效提高了EPS泡沫混凝土的抗动态冲击与吸能能力。

供稿:张文华、李强 供图:张文华 编辑:丁志锋




